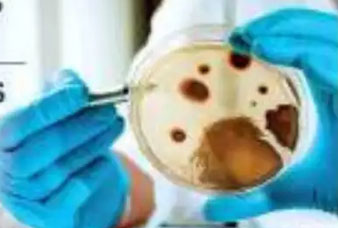
Generic placeholder image

Mucormycosis යනු ඉතා දුර්ලභ ආසාදනය වාතයේ මෙන්ම නිරෝගී මිනිසුන්ගේ නාසය සහ ශ්ලේෂ්මලවල පවා දක්නට ලැබෙන බව පැවසෙන වෛද්යවරුන් මේ ආසාදනය වීමෙන් කොරෝනා රෝගීන් ආබාධිත තත්වයට පත් කරන බවට තොරතුරු අනාවරණය වී තිබෙනවා. මෙම ආක්රමණශීලී ආසාදනය නාසය, ඇස සහ සමහර විට මොළයට බලපාන බවත්, මේ වන විට මෙම දිලීර ආසාදනය වූ රෝගීන් 40 ක් පමණ දැනටමත් […]
චීනය විසින් අභ්යවකාශ ගත කළ ‘ලෝන්ග් මාච් 5B’ රොකට්ටුවේ සුන්බුන් මේ වන විට ඉන්දියන් සාගරයට පතිත වී ඇතැයි විදෙස් වාර්තා සඳහන් කරනවා. චීනය විසින් අභ්යවකාශ ගත කල රොකට්ටුවක් පසුව ඔවුන්ගේ පාලනයෙන් මිදී පෘථිවිය දෙසට පතිත වීමේ අවදානමක් ඇති බව වාර්තා වුණා. මේ වන විටත් එම යානයේ සුන්බුන් මාලදිවයිනට බටහිරින් ඉන්දියානු සාගරයට එම සුන්බුන් කොටස් ඇඳ […]
දිවයින පුරා ස්ථාන ගණනාවක නායයෑමේ අවදානමක් පවතින බව ජාතික ගොඩනැගිලි පර්යේෂණ සංවිධානය පවසනවා. ඒ අනුව නායයාමේ අවදානමට ලක්විය හැකි ස්ථාන 147ක් දිවයින පුරා කළ පරීක්ෂණවලදී හඳුනා ගෙන ඇති අතර රත්නපුර ,කළුතර හා මාතර දිස්ත්රික්වල දඋඩරට දුම්රිය මාර්ගයේ ස්ථාන 22 ක් ද ඒ අතර පවතින බවයි එම සංවිධානය වැඩි දුරටත් සදහන් කරන්නේ.
කොවිඩ් -19 වෛරසය ආසාදනයවීමෙන් තවත් පුද්ගලයින් 22ක් මියගොස් ඇති බව සෞඛ්ය සේවා අධ්යක්ෂ ජනරාල් වෛද්ය අසේල ගුණවර්ධණ මහතා සදහන් කරනවා. ඒ අනුව, මෙරටින් වාර්තා වී ඇති මුළු කොවිඩ් මරණ ගණන 786ක් දක්වා ඉහල ගොස් තිබෙනවා.
අද උදෑසන සිට තවත් ප්රදේශ කිහිපයක් හුදකලා කර තිබෙනවා. ඒ අනුව හුදකලා කර ඇති ප්රදේශ, රත්නපුර දිස්ත්රික්කය රක්වාන පොලිස් බලප්රදේශයේ, දොලේකන්ද ග්රාම සේවා වසමරඹුක ග්රාම සේවා වසමකත්ලාන ග්රාම සේවා වසමතණබෙල ග්රාම සේවා වසමඉළුඹකන්ද ග්රාම සේවා වසමපොතුපිටිය දකුණ ග්රාම සේවා වසම කලවාන පොලිස් බලප්රදේශයේ, පනාපොළ ග්රාම සේවා වසමකුඩුමිටිය ග්රාම සේවා වසමකුඩව ග්රාම සේවා වසමදෙල්ගොඩ නැගෙනහිර ග්රාම […]
දිවයිනේ බොහෝ ප්රදේශවලට රාත්රී කාලයේදී වැසි හෝ ගිගුරුම් සහිත වැසි ඇතිවිය හැකි බව කාලගුණ විද්යා දෙපාර්තමේන්තුව සදහන් කරනවා. ඒ අනුවසබරගමුව, මධ්යම, වයඹ, බස්නාහිර සහ ඌව පළාත්වලත් මිලිමීටර් 100 ඉක්මවූ තද වැසි ඇති විය හැකි බව කාලගුණ විද්යා දෙපාර්තුමේන්තුව සදහන් කරනවා. ගිගුරුම් සහිත වැසි සමග ඇතිවන අකුණු අනතුරු අවම කර ගැනීමට අවශ්ය පියවර ගන්නා ලෙස කාලගුණ […]
ඉන්දියාවේ, කර්ණාටක ප්රාන්තය සති 2 කට වසා දමා තිබෙනවා. ගෙවුණු පැය 24 ක කාලය තුල හමු වූ කොවිඩ් ආසාදිතයින් සංඛ්යාව 48,781 ක්.
වැඩිම දෛනික කොවිඩ් මරණ ගණනක් ඊයේ මෙරටින් වාර්තා වී තිබෙනවා. එම ගණන කොරෝනා මරණ 19ක්. ඒ අනුව මෙරට කොරෝනා ආසාදිත මරණ සංඛ්යාව සංඛ්යාව 764 දක්වා ඉහළ ගොස් තිබෙනවා.
වහාම ක්රියාත්මක වෙන පරිදි දිස්ත්රික්ක කිහිපයක තවත් ග්රාම නිලධාරි වසම් කිහිපයක් හුදකලා කිරීමට පියවර ගෙන තිබෙනවා. ඒ අනුව, ගම්පහ දිස්ත්රික්කයේවත්තල පොලිස් බලප්රදේශයේ කෙරවලපිටිය ග්රාම නිලධාරි වසමවත්තල ග්රාම නිලධාරි වසමහේකිත්ත ග්රාම නිලධාරි වසමපල්ලියවත්ත දකුණ ග්රාම නිලධාරි වසම මහබාගේ පොලිස් බලප්රදේශයේ කෙරඟ පොකුණ ග්රාම නිලධාරි වසමගල්උඩුපිට ග්රාම නිලධාරි වසමමත්තුමගල ග්රාම නිලධාරි වසම කළුතර දිස්ත්රික්කයේකළුතර දකුණ පොලිස් බලප්රදේශයේනාගොඩ […]
මිලියන 67ක් වන බ්රිතාන්ය ජනගහණයෙන් මිලියන 34.6කට මේ වනවිට කොවිඩ් එන්නතේ පළමු මාත්රාව ලබාදී තිබේ. මිලියන 15කට පමණ දෙවන එන්නත් මාත්රාව ද ලබාදී ඇති බව එරට රජයේ සංඛ්යාලේඛනවල දැක්වේ. වයස අවුරුදු 50 ඉක්මවූ බ්රිතාන්ය ජාතිකයන්ට කොවිඩ් එන්නතේ තෙවැනි මාත්රාව ලබාදීමට මේ වන විට සැලසුම් කර තිබෙනවා.
කොරෝනා ආසාදිතයින් වාර්තා වීම හේතුවෙන් වැලිසර ආර්ථික මධ්යස්ථානය නැවත දැනුම්දෙන තුරු වසා දැමීමට තීරණය කර තිබෙනවා.
දිවයිනේ සියලු පාසල් ,විශ්ව විද්යාල ,පිරිවෙන් ,පෙරපාසල්, සහ උපකාරක පන්ති නැවැත දැනුම් දෙනතුරු වසා දැමීමට තීරණය කර තිබෙනවා.අධ්යාපන අමාත්ය මහාචාර්ය ජී.එල්. පීරිස් මහතා සදහන් කලේ දිවයිනේ උද්ගතව ඇති කොරෝනා වසංගත තත්වය හේතුවෙන් එම තීරණයට එළැඹි බවයි. යළි ආරම්භ කරන දිනය , දින 3 කට පෙර දැනුම්දෙන බව ද අමාත්ය ජී.එල් පීරිස් මහතා වැඩි දුරටත් සඳහන් […]